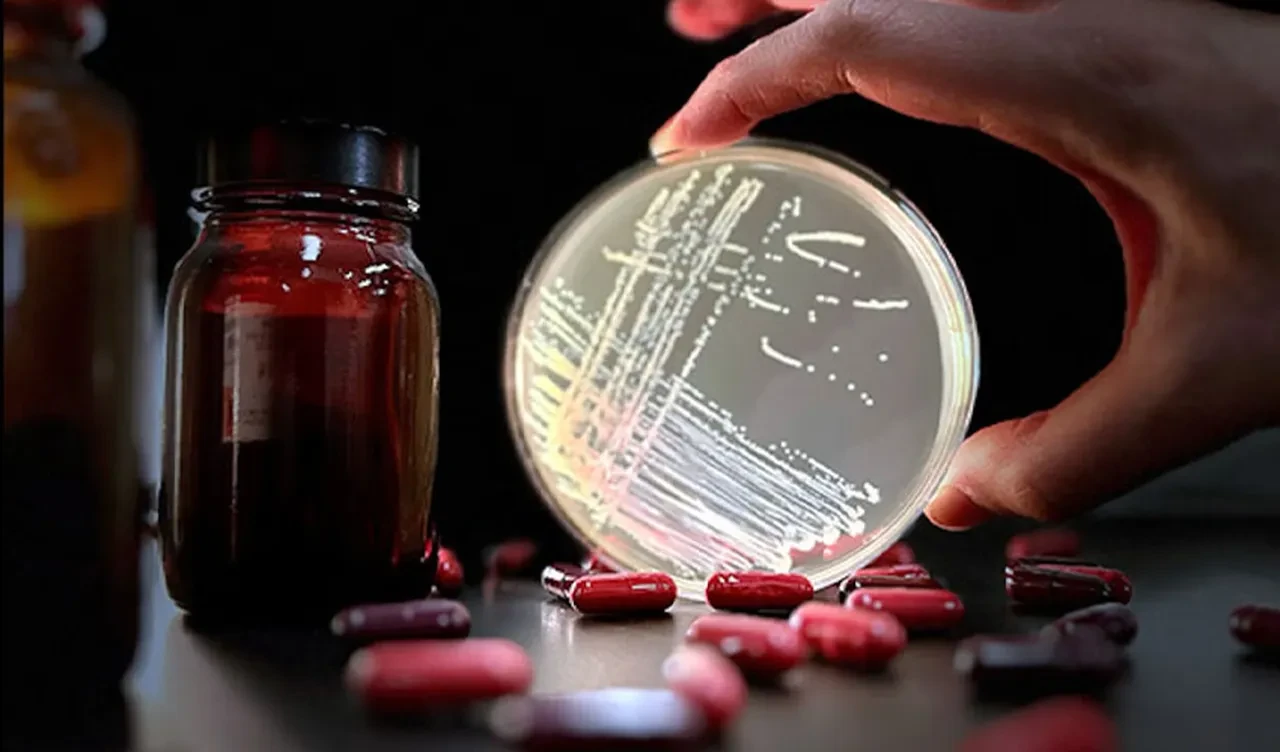
'Süper Antibiyotik' geliştirildi! Milyonlarca hayata umut olacak

Kategoriler
UYGULAMALAR
İstanbul

İsviçre'de zatürre ve sepsis hastalıklarının tedavisi için yeni bir antibiyotik geliştirildi. Yeni antibiyotik insan testlerinin son aşamasına girdi. Milyonlarca hayat kurtarma potansiyeline sahip olduğu belirtiliyor.
İsviçreli ilaç üreticisi Roche, pnömoni (zatürre) ve sepsis (kanda enfeksiyon) gibi ciddi hastane enfeksiyonlarına neden olan yaygın bir bakteriye karşı bir antibiyotiğin testini, üçüncü ve son aşamasına ilerleteceğini duyurdu.
The Independent'te yer alan habere göre, Harvard Üniversitesi ile ortaklaşa geliştirilen "zosurabalpin" adlı antibiyotik, ilaca dirençli "acinetobacter baumannii" bakterisine karşı test edilecek.
Hastalık Kontrol ve Önleme Merkezleri (CDC) acinetobacter baumannii'yi “acil bir tehdit” olarak tanımlıyor, ancak 50 yılı aşkın bir süredir bu bakteriye yanıt veren bir antibiyotik üretilemedi.

Roche, faz 3 çalışmasının, dünyanın dört bir yanından yaklaşık 400 hastanın zosuarbalpin veya standart tedavi almak üzere randomize edildiği tek bir pivotal çalışma olacağını duyurdu.
Roche'un global bulaşıcı hastalıklar başkanı Michael Lobritz, “Amacımız, halk sağlığı açısından en büyük bulaşıcı hastalık sorunlarından biri olan antimikrobiyal direncin üstesinden gelmek için yeni inovasyonlara katkıda bulunmaktır.” ifadelerine yer verdi.

Roche'un bir birimi olan Genentech'in kıdemli başkan yardımcısı ve küresel immünoloji ve ürün geliştirme başkanı Larry Tsai, ilaca dirençli bakterilerin dünyanın her ülkesinde mevcut olduğunu söyledi.
Bu araştırmada yer alan yenilikçi biyolojinin potansiyel olarak bakteri zarlarının yapısına ilişkin yeni bilgiler ortaya çıkarabileceğini ve muhtemelen gelecekte yeni antibiyotiklerin keşfine yol açabileceğini de sözlerine ekledi.
Deneysel ilacın 10 yılın sonuna kadar onaylanması umuluyor.
Küresel olarak, sepsisin her yıl yaklaşık 11 milyon ölüme neden olduğu tahmin ediliyor. Bu her 2,8 saniyede bir ölüme denk geliyor.
Dünya çapında toplum kökenli pnömoni, özellikle yaşlı hastalar arasında yüksek morbidite ve mortalite ile her yıl üç ile dört milyon kişiyi öldürüyor.